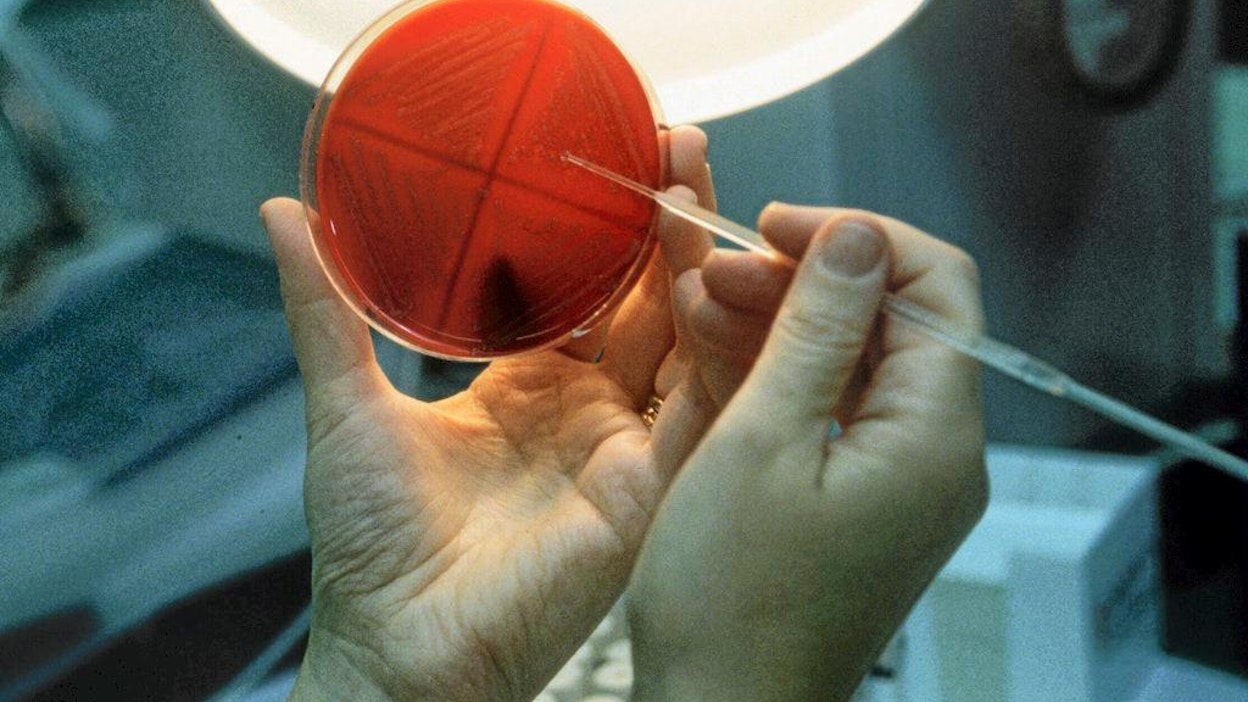

Seinäjoella voi aloittaa elintarvikemaisterin opintopolun
Helsingin yliopiston maatalous- ja elintarvikealan kursseja voi suorittaa Seinäjoella avoimina yliopisto-opintoina. Uusimpana vaihtoehtona on elintarvikemikrobiologia. Maisteriopinnot jatkuvat Helsingissä. Elintarvikealan merkitystä on korostettu alueen strategioissa. Maakunnassa on perinteisesti ollut suhteellisen vähän korkeasti koulutettuja ihmisiä.SEINÄJOKI (MT) Helsingin yliopiston maatalous- ja metsätieteellisen tiedekunnan opintojaksoja on tuotu avoimina yliopisto-opintoina Seinäjoelle vuodesta 2008 lähtien.
”Ideana on tuoda yliopistollista opetusta lähemmäs Etelä-Pohjanmaata. Rakennamme polkua ja siltaa, jota kautta voi jatkaa myöhemmin maisteriopintoihin Helsingin yliopistoon”, koulutuskoordinaattori Katja Perttu Helsingin yliopiston Ruralia-instituutista kertoo.
Vuodesta 2008 alkaen Seinäjoella on järjestetty maatalousekonomian ja -teknologian opintoja, ja uutena pilottina aloitti tällä viikolla elintarvikemikrobiologian opintojakso.
”Toivomme, että elintarviketeknologia on jatkossakin esillä avoimessa yliopistossa. Yksi osa sitä on elintarvikemikrobiologia”, Perttu toteaa.
Opintojaksossa aloitti tällä viikolla miltei 30 opiskelijaa.
Elintarvikemikrobiologian opintojakso on osa METKA-hanketta. Hankkeella haetaan uusia paikallisia toimintamalleja korkea-asteen tutkinto- ja täydennyskoulutuksen toteuttamiselle Etelä-Pohjanmaalla. Yhteistyökumppaneina ovat elintarvikeketjun yritykset ja erilaiset organisaatiot.
Etelä-Pohjanmaalla on perinteisesti ollut suhteellisen vähän korkeasti koulutettuja ihmisiä. Maakunnan kannalta keskeinen elintarvikeala on nostettu esiin useissa alueellisissa strategioissa.
”Puhutaan ruokamaakunnasta, sillä maatalous- ja elintarvikeketjun merkitys on Etelä-Pohjanmaalla suuri. Elintarvikesektorin yhteyteen on hyvä rakentaa uusia avauksia myös koulutuspuolella, kuten METKA-hankkeessa suunniteltujen kaltaisia opintopolkuja.”
Artikkelin aiheet- Osaston luetuimmat